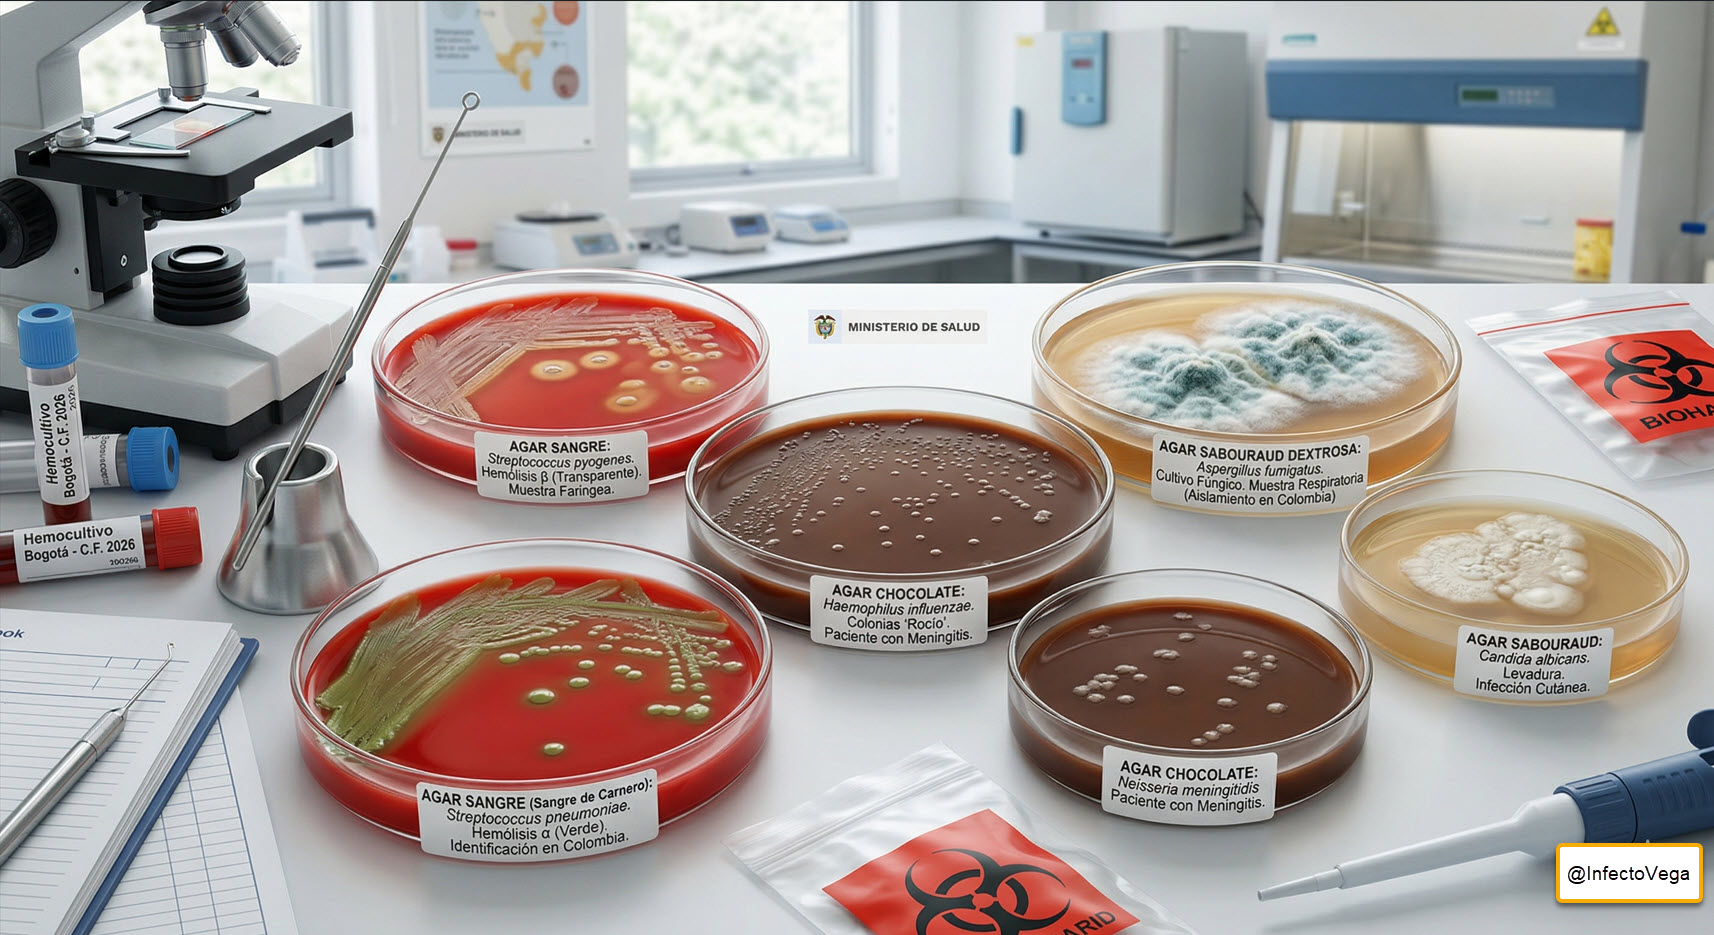
Cultivos microbiológicos. Laboratorio.

Categoría: Prevención y Control infecciones
-
Agustín Vega Vera | Infectólogo | Asesor PROA y Telesalud.

Consulta especializada en infectología de adultos, telemedicina, PROA, IAAS, sepsis y telexperticia. Apoyo clínico y académico para pacientes, médicos e instituciones.
-
Diferencias Clave entre Staphylococcus: S. aureus, S. epidermidis y S. saprophyticus. PREG.

Staphylococcus: diferencias clave entre S. aureus, S. epidermidis y S. saprophyticus Guía clara sobre Staphylococcus: diferencias entre S. aureus, S. epidermidis y S. saprophyticus, virulencia, respuesta inmune, diagnóstico y resistencia. ¿Por qué importa Staphylococcus en clínica? Staphylococcus vive en piel y mucosas. A veces coloniza. A veces infecta. Primero define coagulasa. Luego integra el contexto…
-
Actualización en tratamiento de tuberculosis de adultos

Actualización en Tratamiento de Tuberculosis del Adulto 🫁 Medicina Interna · Infectología · Tisiología Actualización en Tratamiento de Tuberculosis del Adulto Revisión crítica de la literatura · OMS 2022–2025 · ATS/CDC/IDSA 2024–2025 DS-TB · 4 meses MDR/RR · BPaLM Colombia 2025 Contenido · 21 minutos Agenda de la Presentación 📊 1. Epidemiología global y situación…
-
S. aureus bacteriemia

Bacteriemia por S. aureus S. aureus Bacteremia: Clinical Insight STAPHYLOCOCCUS AUREUS BACTEREMIA A Medical Emergency Requiring Precision Management Staphylococcus aureus bacteremia (SAB) is a leading cause of community-acquired and hospital-acquired bloodstream infections. Unlike other pathogens, SAB carries a high risk of metastatic seeding (endocarditis, osteomyelitis). This infographic synthesizes current evidence on burden, management, and outcomes.…
-
Cultivos microbiológicos. Laboratorio.
Medios de cultivo enriquecidos (especiales) en microbiología clínica: cuáles son y qué gérmenes ayudan a recuperar Guía práctica sobre medios de cultivo enriquecidos (agar sangre, chocolate, Sabouraud, Ogawa/LJ): qué gérmenes recuperan y uso clínico en Colombia. Palabra clave: medios de cultivo enriquecidos Actualizado: 26 de diciembre de 2025 ¿Qué es un medio de cultivo enriquecido?…
